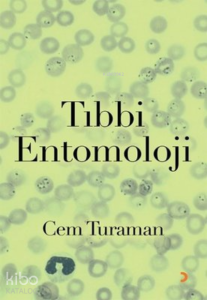
Tıbbi Entomoloji

9786052969359
465117

https://www.sehadetkitap.com/urun/hastaliklarin-kokeni
Hastalıkların Kökeni
567.6
Sanat anlatmak içinse bilim anlamak içindir. Geri kalan bütün disiplin ve öğretiler bu ikisi arasında köprü kurmaya yarar ve eğer insan türünün bir geleceği olacaksa o, bunlardan başka hiçbir şeye ihtiyaç duymayan insan olmak zorundadır. Alet anlık, bilimse uzun vadeli hayatta kalmanın anahtarıdır. Evrimse biyolojinin ruhudur ve bilimin doğasını anlamanın mükemmel bir aracıdır, bilimin anlaşılması evrimin anlaşılmasına bağlıdır ve ikinci bir yol yoktur.
Evrim bize iki temel bilgi ve görev verir: bir, hayatta kalmak için ihtiyaç duyduğumuz enerjiyi en az zararla (ve en eşitlikçi biçimde olmasa da en barışçıl yolla) nasıl temin ederim ve iki, uygun bir eş seçerek genlerimi mutasyonlarıyla birlikte sonsuz geleceğe doğru (en eşitlikçi biçimde olmasa da en barışçıl yolla) naklederek nasıl yaşatırım? Bu iki temel sorunun cevap ipuçlarını yine evrimde buluyoruz, bu metin bu ipuçlarının kitabıdır.
Evrim sadece bir teori ve bilim değil; bir yaşam biçimidir ve uzun ve sağlıklı bir ömrün anahtarıdır. Evrim aynı zamanda, biricik yaşamımıza ne kadar çok ve tüketici biçimde müdahale ettiğimizi ve edildiğini bize söylemektedir; bundan sakınmak da sadece evrimi anlamakla mümkün olabilir. Kitabın tamamında nasıl yaşamamız gerektiğine dair pek çok işaret bulunmaktadır, vücudumuzdaki bütün anatomik oluşumlar ve fizyolojik ve patolojik fenomenlerin evrim hikâyelerinden bu işaretleri çıkartıyoruz. Kendimizi ve hastalıklarımızı anlamanın en etkili yolu evrimi anlamaktır. Vücudumuzun ve toplumumuzun nasıl işlediğini en iyi evrimsel bir bakışla anlayabiliriz ve hastalıklarımızın uzak ve gerçek kökenini anladığımızda onlara farklı bir gözle bakmaya başlarız. Evrim en iyi sağlıklı yaşam rehberi ve hayat öğretmenidir. Nerede nasıl davranmamız, neden gece ışıkları kapatmamız, erken uyumamız, az yememiz, tuz ve şekerden uzak durmamız, bol yürümemiz, sandalyede değil çömelerek dinlenmemiz, kırsalda yaşamamız, besinimizi toprak kuyularda saklamamız, pabuç giymememiz, genç ve yaşlıları gözetmemiz gerektiğini, hepsini evrim bilgisinden öğreniyoruz. Evrimsel tıp konusu henüz çeyrek asır yaşında ve doğumundan bu yana yazılmış, bilgim dâhilinde on kadar kitap var ve bu metin bunların hiçbirine benzemiyor. Bunların çoğu gibi bağımsız bir evrim bölümü kaleme almadan, evrimi tıbba ve seçtiğim hastalık gruplarına içererek tanıttım ve hastalıklar özelinde inceledim, bu yaklaşım kitabı daha dinamik bir hale getirdi, bu kitap hiç değilse bu bakımdan orijinaldir.
Et pişirme becerisi edinme, karbon esaslı bir primatı akıllı kanserlilere dönüştürdü, hâlbuki eti pişirmeden tüketseydik o kadar akıllı ve daha az kanserli olabilirdik, üstelik dişlerimiz daha düzgün olur, barsaklarımız daha iyi çalışırdı. O aklın evrilmesi sayesinde evrimimizi kendi elimize aldık ve pek de iyi etmedik; evrimin yönünü doğaya karşı gelerek etkileyebilen tek türüz ve yeni türler üretmeyi başarıyoruz; düşünme işini çok yakın bir gelecekte karbondan silikona tamamen devrettiğimizde bize kala kala kanser ve yarattığımız gulyabaniler kalmış olacak. Dünyanın canlı ve cansızlar âlemlerine türümüz kadar zarar verebilmiş başka biri yoktur ve böylece son zararımızı kendimize vermek üzereyiz. Antroposentrik bakış sadece insanı tepeye koyduğu için değil; yaşamın büyük kısmını gözden kaçırdığı için de yanlıştır. İnsanı Tanrı'nın yansıması ve diğer bütün canlıların sahibi ve evrenin merkezi ilan eden tek tanrılı dinlerin hiçbirinin onu tüm diğer varlıklarla eşit mertebeye indiren evrimle barışması söz konusu değildir, evrimin de böyle bir kavramı ve konusu yoktur zaten. İktidarların evrimi reddetmelerinin ve öğrenilmesini yasaklamalarının bedeli ise çok ağır olabilir. İnsanlık yeni bir çağın kapısından geçmektedir ve ülkeler tercihlerini hemen yapmak zorundadır. Bu tercih ortalama birkaç bin yaşındaki teizme ya daha sıkı sarılmak ya da ona bir tekme atarak direksiyona geçmek arasında yapılacaktır. Bir kısım ülke ve insan grubu bu kuantum sıçramalarını gerçekleştirirken, enformasyon virajını alamayan ve biyonanoteknoloji çağına adım atamayan yöneticiler ölmüş atlarını kamçılayadursunlar, ülkeleri tarihten silinecektir, vatandaşlarının kaderi ise tükeniştir.
Bu kitabı bir bakıma, sinsi bir ilkelliğin giderek daha küstahça sergilendiği bu akıl dışılık çağında, akılcı ve bilimci tutumda direnmeye kendimi mecbur hissettiğim için yayınlıyorum. Evrim madem liselerden sinsice kovuldu, üniversitelere ve tabii ki önce kendi mesleğimi edindirenlere, yüksek sesle girmelidir. Kitap öncelikle hekimlere ve sağlık ve yaşam bilimi meslek sahiplerine yöneliktir, entellektüel okuyucuya da kapağı açıktır. Dolayısıyla bir popüler kitap değildir ve ‘halk' tarafından anlaşılır olmayı bir değişken olarak dikkate almadım. Kitabın dili de elbette bu mesleklere uygundur, yine de bir sözlük ekledim, meraklısına. Kitabı okuyan sağlık profesyoneli bilgiyi topluma uygulamayı bilecektir.
Sanat anlatmak içinse bilim anlamak içindir. Geri kalan bütün disiplin ve öğretiler bu ikisi arasında köprü kurmaya yarar ve eğer insan türünün bir geleceği olacaksa o, bunlardan başka hiçbir şeye ihtiyaç duymayan insan olmak zorundadır. Alet anlık, bilimse uzun vadeli hayatta kalmanın anahtarıdır. Evrimse biyolojinin ruhudur ve bilimin doğasını anlamanın mükemmel bir aracıdır, bilimin anlaşılması evrimin anlaşılmasına bağlıdır ve ikinci bir yol yoktur.
Evrim bize iki temel bilgi ve görev verir: bir, hayatta kalmak için ihtiyaç duyduğumuz enerjiyi en az zararla (ve en eşitlikçi biçimde olmasa da en barışçıl yolla) nasıl temin ederim ve iki, uygun bir eş seçerek genlerimi mutasyonlarıyla birlikte sonsuz geleceğe doğru (en eşitlikçi biçimde olmasa da en barışçıl yolla) naklederek nasıl yaşatırım? Bu iki temel sorunun cevap ipuçlarını yine evrimde buluyoruz, bu metin bu ipuçlarının kitabıdır.
Evrim sadece bir teori ve bilim değil; bir yaşam biçimidir ve uzun ve sağlıklı bir ömrün anahtarıdır. Evrim aynı zamanda, biricik yaşamımıza ne kadar çok ve tüketici biçimde müdahale ettiğimizi ve edildiğini bize söylemektedir; bundan sakınmak da sadece evrimi anlamakla mümkün olabilir. Kitabın tamamında nasıl yaşamamız gerektiğine dair pek çok işaret bulunmaktadır, vücudumuzdaki bütün anatomik oluşumlar ve fizyolojik ve patolojik fenomenlerin evrim hikâyelerinden bu işaretleri çıkartıyoruz. Kendimizi ve hastalıklarımızı anlamanın en etkili yolu evrimi anlamaktır. Vücudumuzun ve toplumumuzun nasıl işlediğini en iyi evrimsel bir bakışla anlayabiliriz ve hastalıklarımızın uzak ve gerçek kökenini anladığımızda onlara farklı bir gözle bakmaya başlarız. Evrim en iyi sağlıklı yaşam rehberi ve hayat öğretmenidir. Nerede nasıl davranmamız, neden gece ışıkları kapatmamız, erken uyumamız, az yememiz, tuz ve şekerden uzak durmamız, bol yürümemiz, sandalyede değil çömelerek dinlenmemiz, kırsalda yaşamamız, besinimizi toprak kuyularda saklamamız, pabuç giymememiz, genç ve yaşlıları gözetmemiz gerektiğini, hepsini evrim bilgisinden öğreniyoruz. Evrimsel tıp konusu henüz çeyrek asır yaşında ve doğumundan bu yana yazılmış, bilgim dâhilinde on kadar kitap var ve bu metin bunların hiçbirine benzemiyor. Bunların çoğu gibi bağımsız bir evrim bölümü kaleme almadan, evrimi tıbba ve seçtiğim hastalık gruplarına içererek tanıttım ve hastalıklar özelinde inceledim, bu yaklaşım kitabı daha dinamik bir hale getirdi, bu kitap hiç değilse bu bakımdan orijinaldir.
Et pişirme becerisi edinme, karbon esaslı bir primatı akıllı kanserlilere dönüştürdü, hâlbuki eti pişirmeden tüketseydik o kadar akıllı ve daha az kanserli olabilirdik, üstelik dişlerimiz daha düzgün olur, barsaklarımız daha iyi çalışırdı. O aklın evrilmesi sayesinde evrimimizi kendi elimize aldık ve pek de iyi etmedik; evrimin yönünü doğaya karşı gelerek etkileyebilen tek türüz ve yeni türler üretmeyi başarıyoruz; düşünme işini çok yakın bir gelecekte karbondan silikona tamamen devrettiğimizde bize kala kala kanser ve yarattığımız gulyabaniler kalmış olacak. Dünyanın canlı ve cansızlar âlemlerine türümüz kadar zarar verebilmiş başka biri yoktur ve böylece son zararımızı kendimize vermek üzereyiz. Antroposentrik bakış sadece insanı tepeye koyduğu için değil; yaşamın büyük kısmını gözden kaçırdığı için de yanlıştır. İnsanı Tanrı'nın yansıması ve diğer bütün canlıların sahibi ve evrenin merkezi ilan eden tek tanrılı dinlerin hiçbirinin onu tüm diğer varlıklarla eşit mertebeye indiren evrimle barışması söz konusu değildir, evrimin de böyle bir kavramı ve konusu yoktur zaten. İktidarların evrimi reddetmelerinin ve öğrenilmesini yasaklamalarının bedeli ise çok ağır olabilir. İnsanlık yeni bir çağın kapısından geçmektedir ve ülkeler tercihlerini hemen yapmak zorundadır. Bu tercih ortalama birkaç bin yaşındaki teizme ya daha sıkı sarılmak ya da ona bir tekme atarak direksiyona geçmek arasında yapılacaktır. Bir kısım ülke ve insan grubu bu kuantum sıçramalarını gerçekleştirirken, enformasyon virajını alamayan ve biyonanoteknoloji çağına adım atamayan yöneticiler ölmüş atlarını kamçılayadursunlar, ülkeleri tarihten silinecektir, vatandaşlarının kaderi ise tükeniştir.
Bu kitabı bir bakıma, sinsi bir ilkelliğin giderek daha küstahça sergilendiği bu akıl dışılık çağında, akılcı ve bilimci tutumda direnmeye kendimi mecbur hissettiğim için yayınlıyorum. Evrim madem liselerden sinsice kovuldu, üniversitelere ve tabii ki önce kendi mesleğimi edindirenlere, yüksek sesle girmelidir. Kitap öncelikle hekimlere ve sağlık ve yaşam bilimi meslek sahiplerine yöneliktir, entellektüel okuyucuya da kapağı açıktır. Dolayısıyla bir popüler kitap değildir ve ‘halk' tarafından anlaşılır olmayı bir değişken olarak dikkate almadım. Kitabın dili de elbette bu mesleklere uygundur, yine de bir sözlük ekledim, meraklısına. Kitabı okuyan sağlık profesyoneli bilgiyi topluma uygulamayı bilecektir.
Iyzico İle Öde
| Taksit Sayısı | Taksit tutarı | Genel Toplam |
|---|---|---|
| 2 | 283,80 | 567,60 |
| 3 | 189,20 | 567,60 |
Yorum yaz
Bu kitabı henüz kimse eleştirmemiş.